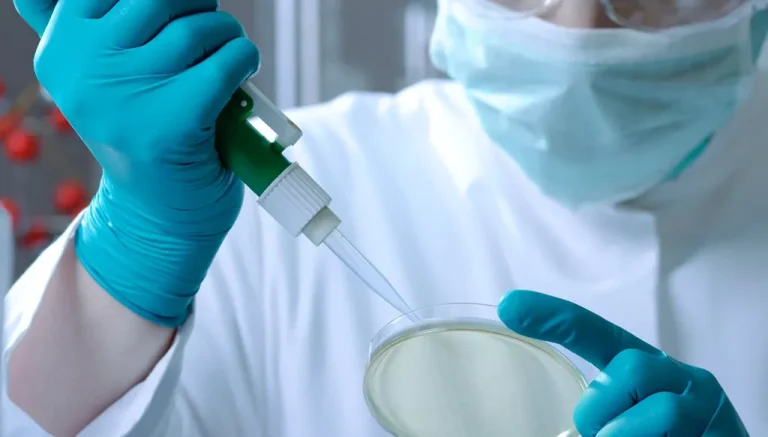
اكتشافات طبيّة ثوريّة شهدناها في عام 2025

اكتشافات طبيّة ثوريّة شهدناها في عام 2025
شهد عام 2025 تحولات كبرى على المستوى الطبي. وعلى الرغم من تراجع مستويات التمويل في مجالات عديدة، كانت اكتشافات عديدة لافتة وتطورات ثورية في غاية الأهمية أعادت الأمل لكثيرين. استطاعت هذه التحولات أن تعيد النظر في مقاربات طبية عديدة وفي سبل الرعاية الطبية التي تقدم للمرضى. حتى أنه في مجال التشخيص وتطوير العلاجات الموجودة أصلاً، كان هناك تقدم لافت على مستوى الأبحاث والدراسات.
ما أبرز الاكتشافات الطبية لعام 2025؟
-علاج ثوري غير هرموني للنساء في مرحلة انقطاع الدورة الشهرية: فيما تواجه نسبة 80 في المئة من النساء مشكلة الهبات الساخنة المزعجة طوال سنوات بسبب المرور بمرحلة انقطاع الدورة الشهرية، ما يؤثر على نمط حياتهن، كان الحل الوحيد المتاح لهن هو العلاج الهرموني. وبرغم أن كثيرين من الأطباء يؤكدون أنه آمن ولا خطورة في اللجوء إليه، كانت هناك تساؤلات عديدة بشأنه. في الوقت نفسه، برغم أن العلاج الهرموني هو الحل الأكثر فاعلية، كثيرات من النساء لا يستطعن اللجوء إليه إذا عانين سابقاً سرطاناً في الثدي أو في الرحم أو مشكلة في القلب. وافقت إدراة الغذاء والدواء الأميركية على علاجين غير هرمونيين يمكن أن تحصل عليهما المرأة في مرحلة انقطاع الدورة الشهرية.
-بخاخ للأنف لمكافحة الحساسية: أصبح هذا العلاج الجديد للحساسية متاحاً للأطفال الذين يعانون حالات متقدمة من حساسية الطعام التي يمكن أن تهدد الحياة. وفي هذا العلاج الجديد الذي يأتي بشكل بخاخ ويجنّب الطفل التعرض لحقنة، ينتقل الدواء مباشرة إلى الدم لدى تلقيه بعد التعرض لنوبة حساسية.
-علاج وقائي من الإيدز: وافقت إدارة الغذاء والدواء الأميركية على حل هو الأول من نوعه للوقاية من انتقال مرض الإيدز. ويمكن للعلاج الذي يعطى بشكل حقنة مرتين في السنة، أن يمنع انتقال كل حالات الإيدز تقريباً كما أظهرت التجارب. واعتبرت منظمة الصحة العالمية أن هذا العلاج الجديد يشكل تطوراً مهماً في مجال الوقاية من الإيدز، ويساعد على الحد من المتابعة الطبية. ويمكن أن يساعد على ضبط المرض لمن أصيبوا به، إلى جانب أدوية أخرى.
-لقاحات لا تحارب الفيروسات فحسب: تم التوصل إلى لقاحات استطاعت أن تحمي العالم من وفيات عديدة ناتجة من أمراض لم يكن من الممكن مواجهتها مثل إنفلونزا وكورونا وشلل الأطفال وغيرها. لكن التطور الحاصل في هذا المجال سمح بتوفير لقاحات يمكن الاستفادة منها على نطاق أوسع مثل الخرف والذبحات القلبية، إضافة إلى اللقاحات الخاصة بالسرطان. فقد تبين أن من تلقوا لقاح الهربس الذي يحمي من الحزام الناري، كانوا أقل عرضة للإصابة بالذبحة القلبية بنسبة 18 في المئة بحسب دراسات عدة. كما أن اللقاح خفض خطر الإصابة بالخرف بمعدل الثلث خلال السنوات الثلاث بعد تلقيه. كما أن مرضى سرطان الرئة والجلد في مراحل متقدمة الذين تلقوا لقاح فيروس كورونا الذي يعتمد على تقنية mRNA شهدوا تحسناً في حالاتهم خلال الأشهر الثلاثة التي تلت بداية تلقيهم العلاج المناعي وكانوا أكثر استجابة للعلاج، إضافة إلى أنهم عاشوا لمدى أطول بالمقارنة مع من لم يتلقوه.
-وقف سرطان البنكرياس قبل بدايته: يعتبر سرطان البنكرياس من أكثر الأورام شراسة وفتكاً بالناس، ويعود ذلك إلى حد ما إلى كونه يُشخص غالباً في مراحل متقدمة. وتقل نسبة المرضى الذين يعيشون أكثر من 5 سنوات بعد التشخيص عن 13 في المئة. في عام 2025، حصل تطور مهم في مجال تشخيص سرطان البنكرياس والوقاية منه بحيث أصبح من الممكن كشف المرض في مراحل مبكرة أكثر. إذ تبين للخبراء أنه من الممكن وقف نشاط بروتين معين يساعد تغذية خلايا سرطان البنكرياس، ما يسمح بالوقاية من الأورام السرطانية في حالات معينة. وبما أن العلاجات التي يمكن أن توقف عمل هذا البروتين أصبحت متوافرة بناءً على تجارب على الفئران، يأمل الخبراء أن يصبح من الممكن الاعتماد عليها مع الأشخاص الذين هم أكثر عرضة للخطر، ومنهم من يواجهون عامل خطر مرتبطاً بالوراثة أو بتاريخ المرض في العائلة. لكن لا تزال هناك حاجة إلى المزيد من التجارب على البشر، لكن التجارب الأولية تبدو واعدة ويمكن أن تنجح هذه العلاجات في الوقاية من المرض